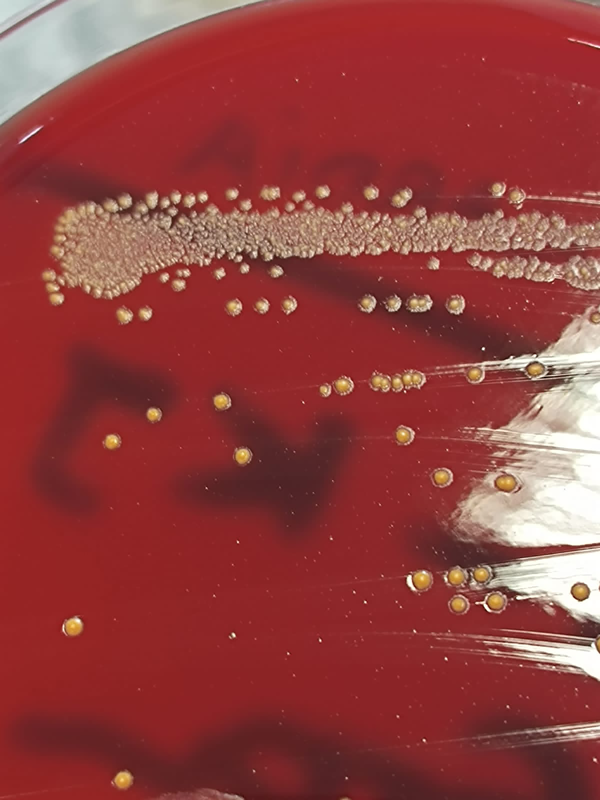

Absceso cerebral por Nocardia
Melisa Medina, Antonella Maidana, Sergio Azcona, Javier Alinez, Nicolás Rodríguez Gacio
Servicio de Neurocirugía, Hospital Escuela “Gral. José de San Martín”, Ciudad de Corrientes, Corrientes, Argentina
Recibido: 01/11/2024. Aceptado: 10/02/2025
Melisa Medina
melimedina006@gmail.com
DOI: 10.59156/revista.v39i01.511
ORCID
Melisa Medina: 0009-0000-1245-8623
Antonella Maidana: 0009-0001-6199-2061
Sergio Azcona: 0009-0003-0469-6324
Javier Alinez: 0009-0003-8683-0186
Nicolás Rodríguez Gacio: 0009-0004-5379-0162
EMAILS
Antonella Maidana: florenciaamaidanaa@gmail.com
Sergio Azcona: sergioazcona_1_8@hotmail.com
Javier Alinez: javieralinez@gmail.com
Nicolás Rodríguez Gacio: nicorodriguezgacio@gmail.com
Los autores no declaran conflicto de interés
Los autores no declaran financiamiento.
RESUMEN
Introducción: los abscesos cerebrales causados por Nocardia spp. son extremadamente raros, representan solo el 2% de todos los abscesos intracraneales reportados en la literatura.
Objetivos: analizar la casuística de nuestra institución y reportar su incidencia regional.
Materiales y métodos: se realizó un estudio retrospectivo y descriptivo de pacientes con diagnóstico de absceso cerebral por Nocardia spp. entre enero de 2021 y diciembre de 2022 en nuestra institución.
Resultados: se identificaron 5 pacientes con absceso cerebral por Nocardia spp., con una edad media de 45.4 años (rango: 29-61). Estos casos representaron el 55.55% de los abscesos cerebrales tratados en el período analizado (n = 9). El 100% de las lesiones se localizaron en el lóbulo frontal, con un 60% en la región precentral. El 80% de los pacientes presentó lesiones múltiples, mientras que el 20% tuvo una lesión única. Tres pacientes manifestaron lesiones pulmonares asociadas.
Conclusión: la incidencia de abscesos cerebrales por Nocardia spp. en nuestra casuística (55.55%) fue significativamente mayor a la reportada en la literatura (2%). Se destaca la importancia de considerar esta etiología en la práctica clínica. El tratamiento fue exitoso en el 60% de los casos.
Palabras clave: Absceso. Neurocirugía. Nocardia. Tratamiento.
Brain abscess due to Nocardia
ABSTRACT
Background: brain abscesses caused by Nocardia spp. are extremely rare and represents only 2% of all intracranial abscesses reported in literature.
Objectives: to analyze the case series of our institution and to report its regional incidence.
Methods: a retrospective and descriptive study of patients diagnosed with brain abscess due to Nocardia spp. was conducted between January 2021 and December 2022 at our institution.
Results: five patients with brain abscess due to Nocardia spp. were identified, with a mean age of 45.4 years (range: 29-61). These cases represented 55.55% of the brain abscesses treated in the analyzed period (n = 9). One hundred percent of the lesions were in the frontal lobe, with 60% in the precentral region. Eighty percent of patients had multiple lesions, while 20% had a single lesion. Three patients had associated lung lesions.
Conclusion: the incidence of brain abscesses due to Nocardia spp. in our case series (55.55%) was significantly higher than that reported in the literature (2%), highlighting the importance of considering this etiology in clinical practice. The treatment was successful in 60% of cases.
Keywords: Abscess. Neurosurgery. Nocardia. Treatment.
INTRODUCCIÓN
El absceso cerebral es una enfermedad infecciosa común y una condición intracraneal severa. Las tasas de morbilidad y mortalidad asociadas se han reducido en las últimas décadas.1 Tienden a ocurrir con una frecuencia considerablemente mayor en pacientes inmunocomprometidos.2
Las bacterias patógenas que se encuentran en un absceso entran al tejido cerebral a través de la diseminación hematógena, por contigüidad o por infección traumática en pacientes con traumatismo craneoencefálico o cirugía.1
Hablando específicamente de los abscesos cerebrales por Nocardia, estos son extremadamente raros y comprenden solo el 2% de todos los casos de abscesos intracraneales y su tasa de mortalidad es del 31%, considerablemente mayor que la de otros de gérmenes (<10%).2 El espectro de infección del SNC por este germen varía desde la infiltración cerebral difusa, meningitis, infección de la médula espinal o el absceso cerebral.2
Se caracterizan por ser bacterias aeróbicas, gram positivas, ramificadas y filamentosas que pueden introducirse en un huésped a través de la inhalación (Figuras 1 y 2). También puede ocurrir a través de la inoculación traumática directa en la piel y la diseminación hematógena desde la ubicación primaria hasta el sistema nervioso central donde se forma un absceso cerebral.1
Figura 1. Desarrollo de Nocardia spp. en agar sangre.

Figura 2. Fotografía de imagen microscópica de Nocardia spp. donde se evidencian filamentos característicos de dicho patógeno.
Se distingue por afectar a los pulmones con más frecuencia que al sistema nervioso central.
Las lesiones suelen ser supratentoriales y multiloculadas debido a la coalescencia de múltiples abscesos.3 La aparición de nocardiosis en un paciente inmunocompetente es rara, por lo que se debe descartar la inmunosupresión por cualquier causa. Se han encontrado casos de nocardiosis en ausencia de factores de riesgo, por ello, ante el compromiso pulmonar o extrapulmonar, se debe sospechar la infección y considerar los estudios microbiológicos o moleculares adicionales para un diagnóstico adecuado.4
En la actualidad, no existen guías clínicas para el tratamiento de primera línea.3 La combinación de trimetoprima-sulfametoxazol (TMS), amikacina, ceftriaxona o carbapenémicos ha sido la elección en casos graves de nocardiosis, aunque no se han realizado ensayos aleatorios para comparar la eficacia de diferentes regímenes de antibióticos para esta entidad, lo que demuestra que es una enfermedad grave que requerirá tratamiento que puede alcanzar el año de duración.
Objetivos
Analizar la casuística de nuestra institución y reportar su incidencia regional.
MATERIALES Y MÉTODOS
Se presenta un estudio retrospectivo de tipo descriptivo de pacientes con absceso cerebral por Nocardia spp. atendidos en el período comprendido entre enero de 2021 y diciembre de 2022 en nuestra institución (Tabla 1).
TABLA 1. VARIABLES ANALIZADAS
Variables analizadas |
Edad |
Localización de la lesión |
Factores de riesgo presentes en el individuo (intrínsecos o extrínsecos) |
Tiempo de evolución |
Tipo de tratamiento establecido |
Evolución postratamiento |
Criterios de inclusión:
Criterios de exclusión:
RESULTADOS
En el período estudiado, el total de abscesos cerebrales diagnosticados y tratados fue de 9, de los cuales 5 (55.55%) fueron causados por Nocardia y 4 debieron ser excluidos por presentar otra etiología distinta.
El tiempo de evolución promedio desde el inicio de síntomas hasta la consulta fue de 23 días (rango 45-10 días). En nuestra serie todos presentaban factores de riesgo (Tabla 2, Figura 3).
TABLA 2. FACTORES DE RIESGO HALLADOS EN LOS PACIENTES CON ABSCESO POR NOCARDIA SPP.
Factores de riesgo |
Recolector de residuos |
Agricultor |
Drogadicción |
Paciente código B24 |
Diabético |

Figura 3. División de factores de riesgos en intrínsecos (inherentes a la persona) y extrínsecos (relacionados al entorno del paciente).
La edad media de estos pacientes con absceso cerebral por nocardia fue de 45.4 años (rango 29-61) y la mediana fue de 43 años. Todos presentaron déficit motor en su evolución (Figura 4).

Figura 4. Síntomas iniciales de los pacientes con diagnóstico de absceso cerebral por Nocardia spp.
El 100% de las lesiones se ubicaron a nivel del lóbulo frontal. El 60%, a nivel precentral. El 80% presentaba lesiones múltiples y solo el 20% (1 paciente) manifestó lesión única; 3 pacientes tuvieron lesiones pulmonares asociadas (Figura 5).

Figura 5. Tomografía de tórax sin contraste que evidencia compromiso pulmonar asociado en paciente con diagnóstico de absceso cerebral por Nocardia spp.
La evacuación del absceso se realizó mediante estereotaxia en 3 pacientes y en 2 de manera convencional por presentar signos de HTE.
DISCUSIÓN
Mientras que Cristina Corsini Campioli y cols. en su artículo titulado “Clinical presentation, management, and outcomes of patients with brain abscess due to Nocardia species” define a los abscesos cerebrales por Nocardia como extremadamente infrecuentes, comprendiendo solo el 2% de todos los abscesos intracraneales, en nuestra serie de casos los abscesos por Nocardia representaron un 55.55% del total de abscesos tratados en el período de tiempo estipulado para este trabajo. Esto refleja la gran variabilidad regional respecto a la frecuencia de los distintos gérmenes, algo fundamental a tener en cuenta para el inicio de esquemas antibióticos empíricos hasta la obtención de los resultados remitidos a bacteriología.
Si bien Jian-Wei Zhu y cols. y Huamaní-Charagua y cols. describen que esta entidad suele presentarse en pacientes inmunodeprimidos, ellos reportan, respectivamente, el caso de un paciente inmunocompetente considerándolo infrecuente; sin embargo en nuestra serie de 5 pacientes solamente uno era inmunosuprimido (infectado por VIH), y el resto presentaba factores de riesgos para infección por Nocardia, pero no inmunocomprometido.
Respecto al régimen de antibióticos instituidos en el postoperatorio y su duración, pese a no existir una guía que indique un tratamiento de primera línea, en conjunto con el servicio de infectología de nuestra institución se ha determinado la utilización de trimetoprima-sulfametoxazol (TMS), ceftriaxona e imipenem, con una duración total de un año con seguimientos mensuales por neurocirugía e infectología, seguimiento clínico, de laboratorio y de imágenes, lo cual coincide con la bibliografía donde la terapia antibiótica empírica más comúnmente utilizadas sola y/o en combinación fue TMS en el 41.6% de los casos, seguida de vancomicina (37.5%), linezolid (33.3%), metronidazol (33.3%) y meropenem (21.1%). La duración media de la terapia antibiótica parenteral fue de 21 días. La duración media final del antibiótico fue de 322 (180.5–365) días.2 No realizamos medicación intratecal a ninguno de los pacientes reportados, a diferencia de lo descripto por Einstein y cols.5
Finalmente, aunque se informó que la tasa de mortalidad de los abscesos cerebrales por Nocardia es de hasta un 30%, en comparación con el 10% de otras causas bacterianas, no presentamos casos fatales en nuestra serie.
CONCLUSIÓN
Las poblaciones de mayor edad, inmunocomprometidas y con morbilidades asociadas tienen un mayor riesgo de abscesos cerebrales por Nocardia.
La evacuación temprana permite confirmar el diagnóstico, elegir un régimen antimicrobiano apropiado, y reducir la morbilidad y mortalidad debido al control temprano y adecuado de la infección, lo cual hace fundamental el trabajo en conjunto de servicios de bacteriología, neurocirugía, infectología, clínica médica y diagnóstico por imágenes.
Hemos constatado una mayor prevalencia de abscesos causados por Nocardia (55.55%) respecto a la bibliografía consultada (2%), sumado a una constancia en la ubicación de las lesiones a nivel del lóbulo frontal. Tras este trabajo podemos resaltar la importancia de tener en cuenta esta etiología ante abscesos cerebrales en nuestra área geográfica en particular.
El tratamiento establecido (evacuación más posterior inicio inmediato de antibioticoterapia) resultó favorable en el 60% de los pacientes. Uno abandonó el tratamiento y otro, el paciente de mayor edad de nuestra serie, evolucionó de manera regular.
Agradecimientos
Agradecemos al Servicio de Infectología; al Servicio de Bacteriología por las imágenes aportadas y al Servicio de Neumología y Clínica Médica.
Contribuciones de autoría
Conceptualización: Melisa Medina.
Curación de datos: Melisa Medina. Sergio Azcona.
Análisis formal: Melisa Medina. Nicolás Rodríguez Gacio.
Adquisición de fondos: Melisa Medina.
Investigación: Melisa Medina.
Metodología: Melisa Medina. Javier Alinez.
Administración del proyecto: Javier Alinez.
Recursos: Antonella Maidana.
Software: Antonella Maidana.
Supervisión: Javier Alinez.
Validación: Javier Alinez.
Visualización: Melisa Medina.
Redacción - borrador original: Melisa Medina.
Redacción - revisión y edición: Melisa Medina.
Este es un artículo de acceso abierto bajo la licencia CC BY-NC https://creativecommons.org/licenses/by-nc/4.0/
BIBLIOGRAFÍA
COMENTARIO
Los autores presentan un estudio retrospectivo sobre una serie de casos diagnosticados con abscesos cerebrales por Nocardia en una misma institución en el norte argentino.
Considero destacar 3 puntos dentro de lo desarrollado en el artículo:
Primero, las infecciones bacterianas por este género (Nocardia spp.), como bien se plantea en el escrito, son poco frecuentes y han sido documentadas en inmunocomprometidos; en pacientes con HIV representan entre el 0.1 y 0.3% de incidencia global. En pacientes con grados más avanzados de inmunocompromiso, se pueden observar formas pulmonares y diseminadas. Los síntomas generales suelen ser insidiosos, por lo cual hace dificultoso arribar al diagnóstico, incluso cuando los modernos métodos de imágenes han cambiado este paradigma ante la sospecha clínica. Para los casos reportados en el trabajo, del total de pacientes con diagnóstico de certeza por Nocardia (n = 5) solo 1 presentaba HIV. Esto nos obliga a pensar que debemos tener en cuenta otros factores de riesgo que predisponen a este tipo de infección y que no son menos importantes.
En segundo lugar, cabe mencionar el período de tiempo en los que se han registrado los casos (enero 2021 a diciembre 2022). Considero que no es un dato menor tratándose de una patología poco frecuente (con alta incidencia regional), por lo que hace destacable la publicación.
Otro punto importante es que las infecciones por este patógeno presentan una mortalidad más elevada en comparación a otras entidades que causan abscesos cerebrales con mayor frecuencia. En los pacientes de la serie descripta por los autores, los resultados han sido favorables, demostrando un diagnóstico temprano y un tratamiento efectivo.
Quedará para otra ocasión comentar la utilidad de la biopsia estereotáxica como herramienta para la obtención de material en contraposición a la cirugía convencional (dependiendo esto de la ubicación topográfica de la lesión cerebral, ya sea única o múltiple) así como los distintos enfoques terapéuticos.
Por último, quiero felicitar a los autores por los resultados obtenidos y alentarlos a que sigan ampliando la serie con otros reportes.
Dr. Emiliano Lorefice
Sanatorio Anchorena y Sanatorio Otamendi y Miroli, CABA, Argentina